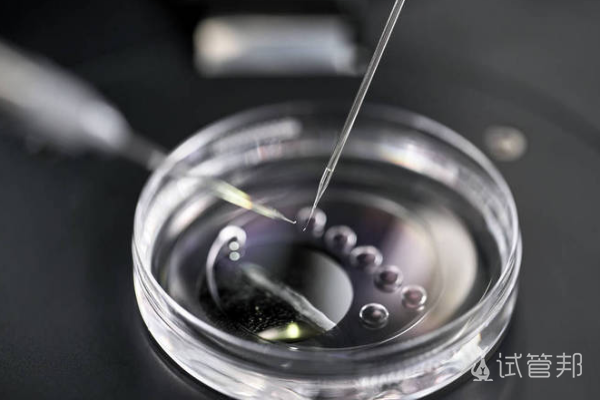

试管婴儿是一种辅助生殖技术,可以帮助那些自然怀孕困难的夫妇实现生育愿望。很多不孕不育夫妻都选择做了试管婴儿。但不同地区的试管婴儿花费和流程可能存在一定的区别,因此在做试管婴儿之前,夫妻双方需要提前了解这些信息,做好准备工作。下面就将详细介绍重庆做试管婴儿的费用和流程。

重庆做试管婴儿要多少钱?
重庆做试管婴儿的费用因医院和治疗方案不同而有所差异。一般来说,费用包括以下几个方面:
1、体检费用:在进行试管婴儿前,需要进行一系列的体检,包括男女双方的生殖系统检查、血液检查、内分泌检查等。体检费用一般在1000元左右。
2、药品费用:试管婴儿需要使用一些促排卵药物、促黄体生成素等药物,这些药物的费用一般在5000元左右。
3、手术费用:试管婴儿手术的费用一般在1万元左右。
4、其他费用:包括住院费、手术后的护理费、检查费等,一般在5000元左右。
总体来说,重庆做试管婴儿的费用大约在2万元左右。
重庆做试管婴儿具体有哪些流程
1、初诊:夫妻双方到医院进行初诊,医生会根据夫妻双方的情况制定治疗方案。
2、体检:夫妻双方需要进行一系列的体检,包括男女双方的生殖系统检查、血液检查、内分泌检查等。
4、取卵:在卵子成熟后,医生会进行取卵手术,将卵子取出。
5、取精:男方需要提供精液,医生会进行精液处理,筛选出精子。
7、移植:将受精卵移植到女方子宫内。
8、观察:进行观察,确认是否成功妊娠。
9、分娩:如果妊娠成功,进行分娩。
试管邦温馨提示:在重庆做试管婴儿的流程比较复杂,需要夫妻双方重视医院和医生的选择,提前做好准备工作。同时在做试管婴儿的过程中要积极的配合和医生的精心治疗。同时夫妻双方需要注意身体保健和心理调节,才能尽量提高试管婴儿的成功率。
